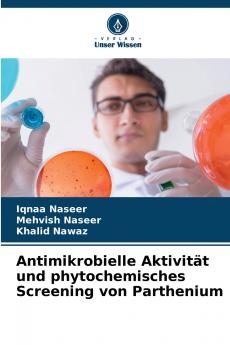
Antimikrobielle Aktivität und phytochemisches Screening von Parthenium

German
Paperback
₹7600
₹10039
24.3% OFF
(All inclusive*)
Delivery Options
Please enter pincode to check delivery time.
*COD & Shipping Charges may apply on certain items.
Review final details at checkout.
Looking to place a bulk order? SUBMIT DETAILS
About The Book
Description
Author(s)
Die heilenden Eigenschaften von Pflanzen sind auf das Vorhandensein von Sekundärmetaboliten zurückzuführen die als Schutzmechanismus dienen um den Pflanzenkörper vor schädlichen Organismen zu schützen. Es wurde vermutet dass Parthenium hystrophours eine überzeugende antibakterielle und antimykotische Wirkung hat daher wurde die vorliegende Studie durchgeführt um die antibakterielle und antimykotische Wirkung sowie das phytochemische Screening dieser Pflanze zu untersuchen. Die untersuchte Pflanze wurde in drei Lösungsmittel nämlich Methanol Ethanol und Wasser gegeben nachdem sie in Pulverform umgewandelt worden war um pflanzliche organische Extrakte herzustellen. Die antibakterielle Aktivität wurde mittels Ager-Well-Diffusionstest gegen zwölf Bakterienstämme bestimmt: Escherichia coli 1 Escherichia coli 2 Escherichia coli 3 Neisseria gonorrhoeae Streptococcus pyogenes Enterobactor aerogenes Shigella sonnei Micrococcus luteus Bacillus subtilis Staphylococcus aureus 1 Staphylococcus aureus 2 und Klebsiella pneumonia. Es wurde auch ein sehr neuartiger Parameter angewendet der den Einfluss der Zeit auf die Dosierung des Extrakts zur Hemmung des Bakterienwachstums untersuchte um die Wirksamkeit des pflanzlichen Roharzneimittels zu bestimmen.
Delivery Options
Please enter pincode to check delivery time.
*COD & Shipping Charges may apply on certain items.
Review final details at checkout.
Details
ISBN 13
9786209232299
Publication Date
-12-12-2025
Pages
-84
Weight
-127 grams
Dimensions
-152x229x5.11 mm